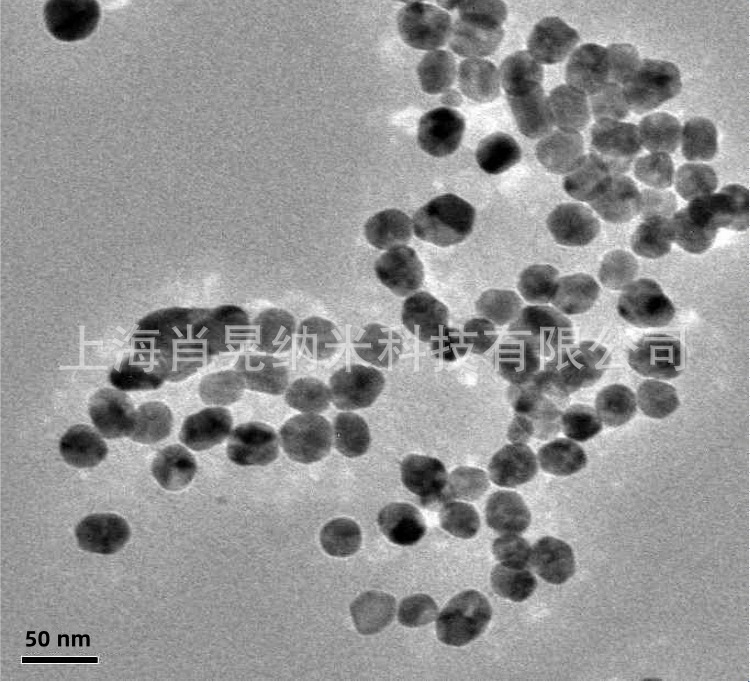
undefined

|





| 品牌 | 肖晃纳米 |
| 货号 | XH-WO3-50 |
| 型号 | XH-WO3 |
| 外观 | 用于生产金属钨制品 |
| 包装规格 | 100g/500g/1kg/5kg |
| 纯度 | 99.9-99.999% |
| CAS编号 | 1314-35-8 |
| 别名 | 三氧化钨 |
| 执行质量标准 | 企业标准 |
| 厂家(产地) | 上海 |
产品介绍:
产品纯度高,粒径小,分布均匀,比表面积大,高表面活性,松装密度低;不
产品参数:
| 产品归类 | 货号 | 平均粒径 | 纯度(%) | 形貌 | 颜色 |
| 纳米级 | XH-WO3-30 | 30nm | >99.9 | 球形 | 蓝色/黄色 |
| 纳米级 | XH-WO3-50 | 50nm | >99.9 | 球形 | 蓝色/黄色 |
| 亚微米级 | XH-WO3-500 | 500nm | >99.9 | 不规则 | 黄色 |
| 亚微米级 | XH-WO3-800 | 800nm | >99.9 | 不规则 | 黄色 |
| 微米级 | XH-WO3-001 | 1um | >99.9 | 不规则 | 黄色 |
| 微米级 | XH-WO3-003 | 3um | >99.9 | 不规则 | 黄色 |
| 本公司可根据客户要求提供不同粒径和纯度的微纳米粉体定制生产 | |||||
产品应用:
1、氧化钨做为一种中间产品被用于金属钨粉和碳化钨粉,进而用于生产金属钨制品。
2、氧化钨具有气体敏感性。已经制备了氧化钨薄膜气敏传感器和氧化钨的纳米颗粒传感器,纳米传感器的发现大大的提高了对于低浓度有毒气体的检测。
包装储存:
本品为充惰气塑料袋包装,密封保存于干燥、阴凉的环境中,不宜暴露空气中,防受潮发生氧化团聚,影响分散性能和使用效果;包装数量可以根据客户要求提供,分装。
产品实拍:


电镜数据:

返回顶部